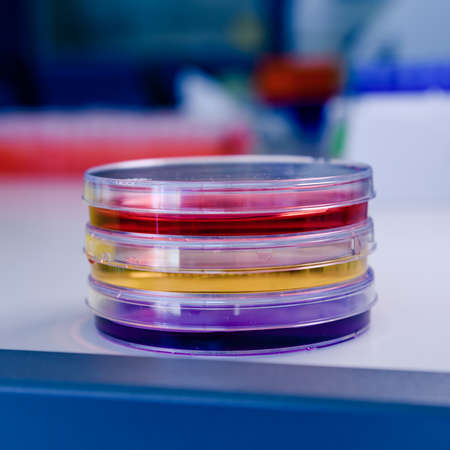
Tower of petri dishes with different dyes and tests. Concept of science, laboratory and study of diseases.の写真素材

写真素材 - Tower of petri dishes with different dyes and tests. Concept of science, laboratory and study of diseases.
作品情報
Tower of petri dishes with different dyes and tests. Concept of science, laboratory and study of diseases.
- ID:142761728
- 作品種別:写真
- 作者名:dhdezvalle
キーワード
- Biology
- Concept
- Culture
- analyzing
- bacterial
- biochemistry
- biological
- bioscience
- biotechnology
- chemistry
- colony
- color
- coronavirus
- covid-19
- development
- disease
- diseases
- equipment
- experiment
- genetics
- glove
- growth
- hand
- health
- healthcare
- infection
- innovation
- investigation
- lab
- laboratory
- medical
- medicine
- microbial
- microbiology
- microorganism
- molecular
- organism
- pathology
- petri
- pharmaceutical
- pharmacology
- pipette
- research
- sample
- science
- scientific
- study
- test
- treatment
- virus
類似作品
Black Spaghetti...
Collage of diff...
Modern Lasagna ...
Close up to del...
Eid Mubarak Mus...
Halal chinese f...
Buffet table wi...
A street food v...
Chef holding a ...
Professional ch...
Joyful office H...
Chef cook pours...
A view of weddi...
Discover a stun...
Close-up of che...
Skilled chef pr...
Delicious Delig...
Top view of Hap...
dinner in the l...
The chef prepar...
A man in a kitc...
Greative and fu...
very delicious ...
Food stylist pr...
A delicious ser...
Korea BBQ style...
The chef prepar...
Lush Vegetarian...
A skilled chef ...
high angle shot...
A chef plating ...
Traditional Din...
A street vendor...
Seafood platter...
chef presenting...
A gourmet sushi...
The chef prepar...
Vegetable salad...
Festively set t...
Immerse yoursel...
Top view on the...
Waitress Behind...
A close-up of a...
Thick steam obs...
Top of view ful...
Italian cuisine...
Chef garnishing...
A set of gourme...